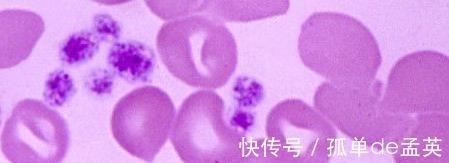
淋巴细胞|血常规,能不能检查出癌症提醒4个指标有异常,要做详细检查

淋巴细胞|血常规,能不能检查出癌症提醒4个指标有异常,要做详细检查

文章插图
血常规检查,能否看出患有癌细胞?医院有很多的检查项目,血常规是一个必要的检查项目之一,在所有的疾病当中,都会需要血常规检查,在这个过程当中比较简单,进行血常规检查的时候,医生会在静脉中抽取一些血液,放到医疗器械当中进行检查化验,最终得出血液检查的结果。根据结果,医生可以判断身体的健康状况,癌症是很多人,谈之色变的一种疾病,对于很多人来讲,血常规检查的报告当中不会有任何的变化,只有少数的人群能够通过血常规检查报告看出身体是否有问题。

文章插图
癌症早期以及中期的患者,身体不会有很大变化,仍然在正常的范围之内,如果不及时在医院检查或者治疗,产生的后果不堪想象,如果身体出现癌细胞的恶化,那么血液当中的血小板数量会随之变化,在这个时候可以检查血常规,是可以看出一些问题,肿瘤细胞出现的标志物也会随之增多。血常规检查,发现这4个指标有些异常,要引起重视1、血小板指数在检查单上发现血小板的指数出现异常,不管是高低还是正常的范围之内,都有可能有癌症的现象,因为血小板主要起到的作用是凝血,一般来讲,血小板的数量是平稳的。如果身体当中出现癌细胞的时候,血小板数量会有所变化,起伏会较严重,如果有些常见的骨髓肿瘤,会导致血小板的数量迅速增多,比如肝癌以及胃癌、肺癌等一些癌症,会导致血小板的数量增多,如果通过血常规检查,发现血小板指数飙升,一定要引起注意。

文章插图
2、血小板的含量血小板具有快速凝血的效果,还可以检测出身体是否出现贫血的状况,假如身体某个部位出现伤口出血,但是没有在任何外界条件帮助的情况下,血很快自动凝结,这就说明血小板在血液的含量很高。可是并不是血小板越高越好,含量太高容易出现大出血的情况,最终还会产生其他的各种疾病。
文章插图
3、红细胞人体内很多的红细胞,在检查的时候,医院会根据红细胞的分布以及数量来进行判断,判断疾病的重要参考之一,主要是负责给身体运输氧气,红细胞正常身体的每个器官都能够正常的运转工作,一旦出现问题,说明身体已经开始有疾病出现,患者的精神状态也会有所变化,需要做进一步的检查来进行治疗。4、淋巴细胞指数出现异常通过血常规检查,我们能够发现淋巴细胞的指数异常和判断癌症患病的几率有大有小的关系,当身体当中的淋巴细胞出现问题的时候,一定要提高警惕,是否身体出现了疾病,因为人体当中的血细胞包括了射碱粒细胞,淋巴细胞等一些类型的细胞,其中中粒细胞主要是防御身体的癌细胞侵入。
【 淋巴细胞|血常规,能不能检查出癌症提醒4个指标有异常,要做详细检查】
文章插图
- 消化道出血|肝癌可以治愈吗?早期肝癌有什么症状?晚期肝癌能活多久?
- 心脑血管疾病|高血压患者要健康,少吃以下6种食物!医生:第3种常见,危害最大
- 高血脂|6类食物是高血脂的“天敌”,玉米上榜,排第一的四季都能买到
- 高密度胆固醇|被查出高胆固醇,不想吃药怎么办?分享4点建议,血脂或许会下降
- 患者|高血压患者看过来!引发高血压的6大因素,千万别小看它们
- 腊肉|高血压的,再馋也不能贪吃5个“升压王”食物,不然血压不降反升
- 运动|锻炼真的能降血压,研究已实锤!3类运动,尤其适合高血压病人
- 血压|高血压患者,不想并发症找上门,坚持做好这5点,或能稳定血压
- 奶制品|高血脂的人不能喝奶制品?医生提醒:不想血脂升高,做好这3点
- 并发症|提醒高血压患者:未来若不想并发症找上门,这3种食物尽量别碰!
